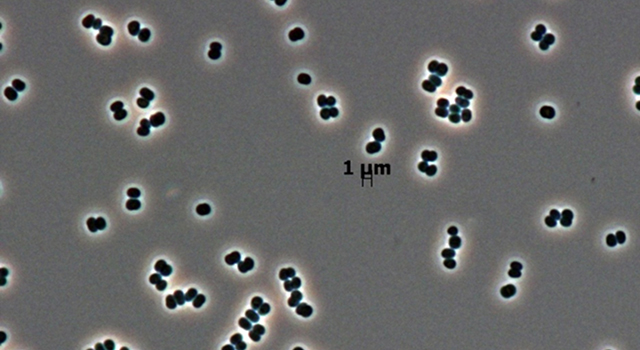
La bacteria descubierta ahora en dos salas blancas distintas. Imagen: NASA/JPL-Caltech

|
Breves21
Un mapa en alta resolución detalla las pérdidas y ganancias de masa forestal del último siglo 15/11/2013La Universidad de Maryland (EE UU) ha liderado un equipo que ha creado el primer mapa global en alta resolución de la superficie forestal global. Esta carta geográfica señala la pérdida y ganancia de masa forestal a partir del año 2000. "Este es el primer mapa sobre la evolución de los bosques globalmente consistente y relevante a nivel local", afirma el profesor de la Universidad de Ciencias Geográficas de Maryland Mateo Hansen, líder del equipo y autor principal del artículo que publica la revista Science. En el estudio han participado un total de quince investigadores universitarios del gobierno de EE UU, en colaboración con la empresa Google. Sus resultados informan de una pérdida mundial de 2,3 millones de kilómetros cuadrados de bosque entre 2000 y 2012, y una ganancia de 800.000 kilómetros cuadrados de masa forestal nueva. Los investigadores construyeron su mapa usando imágenes de satelitales de la superficie de la Tierra a una escala de 30 metros de resolución. Según sus estimaciones, Brasil es el país que menos masa forestal ha perdido durante el siglo XX. Por el contrario, Indonesia muestra la mayor pérdida. Más información SINC
El saola, una rara especie de mamífero de Vietnam, reaparece tras 15 años desaparecido 14/11/2013El saola o buey de Vu Quang, uno de los mamíferos más raros y más amenazados del planeta, ha sido fotografiado en Vietnam por primera vez en 15 años por una cámara trampa instalada por la ONG WWF y el Departamento de Protección Forestal del gobierno vietnamita. Esta nueva imagen es el primer avistamiento saola en estado salvaje en este siglo. "Se trata de un descubrimiento monumental y llega en un momento crítico para la conservación del saola", explica Barney Long, director del Programa de Conservación de Especies de WWF. "Es una gran recompensa por décadas de incansable trabajo por parte del gobierno provincial que estableció la reserva saola, los equipos de eliminación de cepos de la comunidad y los biólogos de WWF. Ahora es el momento de redoblar nuestros esfuerzos para recuperar esta emblemática especie", asegura. Las nuevas imágenes son una poderosa evidencia de la eficacia de los esfuerzos de conservación de hábitats del saola. En el área donde fue fotografiado, WWF ayudó a poner en práctica un innovador modelo de aplicación de la ley en la que los guardas forestales son reclutados en las comunidades locales. Co-dirigido por WWF y el gobierno vietnamita, el programa trabaja para eliminar las trampas y detener la caza ilegal, la mayor amenaza para la supervivencia del saola. Desde 2011, las patrullas forestales han eliminado más de 30.000 trampas del hábitat del saola. El saola ha sido documentado en la naturaleza por parte de los científicos en sólo cuatro ocasiones desde su descubrimiento en 1992. La dificultad de la detección de este animal ha evitado que los científicos hagan una estimación precisa de la población, que se cree que es de unos pocos cientos como máximo y, posiblemente, sólo de unas pocas docenas como mínimo. Más información WWF/T21
Miden las tallas de 1.700 hombres para crear nuevos patrones de ropa europeos 14/11/2013Las tallas de ropa en Francia, España y Portugal no son las mismas. Hacerlas comparables para optimizar la compra de ropa on line en estos países es el objetivo del proyecto europeo SizingSUDOE, para el que investigadores del Instituto de Biomecánica de Valencia (IBV) se disponen a realizar un estudio antropométrico de los hombres españoles. Las medidas se obtienen gracias a una cabina con un escáner dotado de tecnología óptica que registra en 3D la morfología del individuo mediante el uso de láseres durante quince segundos. El IBV, coordinador nacional de esta iniciativa, medirá más de 130 parámetros en 1.700 hombres. El tallaje se realiza en la actualidad en ciudades como Madrid, donde el proceso de selección continúa abierto. Podrán colaborar en este estudio varones mayores de doce años que residan en nuestro país. SizingSUDOE plantea la creación de una red estable entre centros tecnológicos y asociaciones empresariales para facilitar la transferencia de la información antropométrica de la población a las empresas del sector, y de esta manera facilitar que desarrollen nuevos productos y servicios adecuados a todos los consumidores. La obtención de datos tiene múltiples aplicaciones, no solo en el sector del textil y la confección. Contar con las medidas actualizadas de la población permite mejorar el diseño de los puestos de trabajo, del mobiliario, de los automóviles o incluso de las sillas de ruedas. La creciente deslocalización de la producción del sector textil, la aplicación de sistemas de patronaje basados en datos y proporciones corporales de los años 70, así como la escasa estandarización de los sistemas de tallaje, han provocado que una de las principales quejas de los consumidores sea la falta de ajuste de ropa. Unas medidas que afectan especialmente a las mujeres, ya que según las encuestas, un 40% de ellas tiene problemas para encontrar ropa de su talla. “Estas limitaciones son una lacra para el comercio por internet y provocan unas importantes tasas de devolución de producto”, apunta el Instituto de Biomecánica de Valencia. Más información SINC
Hallan una extraña bacteria en salas blancas para naves espaciales 11/11/2013Una rara especie de microbio descubierta recientemente, que sobrevive con muy poco que comer, ha sido encontrada en dos lugares de la Tierra: salas blancas (con bajo nivel de contaminación) para naves espaciales en Florida (EE.UU.) y en la Guayana Francesa (América del Sur). Los microbiólogos suelen hacer búsquedas exhaustivas de bacterias y otros microbios en las salas blancas para naves espaciales. Si alguna vez se encuentra vida extraterrestre, habrá que comprobar si podía haber viajado en el interior de la nave. La nueva bacteria es tan diferente a cualquier otra bacteria conocida, que ha sido clasificada no sólo como una nueva especie, sino también como un nuevo género, el siguiente nivel de clasificación de la diversidad de la vida. Sus descubridores la han llamado Tersicoccus phoenicis . Tersi es la palabra en latín para limpieza. Coccus, del griego para baya, describe la forma de la bacteria. Phoenicis se refiere a Phoenix Mars Lander de la NASA, la nave espacial que se estaba preparando para su lanzamiento en 2007, cuando la bacteria fue descubierta por primera vez analizando el suelo de la sala blanca de Florida. Algunos otros microbios habían sido descubiertos en una sala blanca y en ninguna otra parte, pero nunca habían sido encontrados en dos salas blancas diferentes y en ninguna otra parte. No es raro que estas bacterias no se encuentren fuera, señalan los expertos, porque aunque es probable que también estén, seguramente están ocultas bajo muchas otras especies. Tersicoccus phoenicis podría encontrarse en algún entorno natural con niveles de nutrientes muy bajos, como una cueva o el desierto, señalan los científicos. Es el caso de otra especie de bacteria (Paenibacillus phoenicis) encontrada en una sala blanca de Florida y en una perforación de más de 2,1 kilómetros de profundidad en una mina de molibdeno de Colorado. Más información JPL-NASA/T21
Un quemador de estufa inspirado en la industria aeronáutica ahorra un 25% de gas 08/11/2013Un equipo de emprendedores egresados del Instituto Tecnológico de Celaya en Guanajuato (México) son pioneros en el diseño de quemadores para estufa que ahorran entre el 15 y 25 por ciento de gas y reducen la emisión de contaminantes al ambiente. La tecnología la ha comenzado a producir la empresa Whirlpool de México. Los quemadores de una estufa convencional tienen la llama exterior; en cambio, la tecnología diseñada por los ingenieros Jorge Richard Angulo y Rodrigo Uribe Jiménez es interior: la flama se encuentra dirigida de una manera más precisa y concentra mayor calor. Los quemadores están diseñados con orificios por donde sale el gas, que genera la llama con un ángulo muy específico, y rota el flujo de energía por debajo de lo que se está calentando, es decir, que el quemador aprovecha más la energía. Angulo y Uribe Jiménez tomaron ideas de la industria aeronáutica y de los quemadores a gran escala. Más infomación Investigación y Desarrollo
Un dispositivo utiliza la ionización y el magnetismo para reducir la contaminación 08/11/2013Iberdrola Ingeniería, la Universidad de Salamanca (USAL) y el Centro de Láseres Pulsados (CLPU) de la ciudad salmantina realizaron el martes una demostración de los primeros resultados del proyecto de I+D denominado Sigma, centrado en el desarrollo de sistemas avanzados de separación de gases atmosféricos por ionización y magnetismo y su aplicación en la captura de CO2. Sigma, informa una nota de prensa de Iberdrola recogida por el Instituto de la Ingeniería de España, pretende reducir casi al 100% las emisiones de las centrales convencionales de generación de energía eléctrica y las plantas industriales. Dicho equipo conseguirá que, mediante radiación láser ultracorta-ultraintensa, se ionicen de forma eficiente los gases contaminantes generados en estas instalaciones, para posteriormente extraerlos a través de campos eléctricos y magnéticos, tratarlos y utilizarlos como materias primas en otras industrias, como empresas fertilizantes o de conservas de alimentos. Más información IIE/T21
El caso de coronavirus detectado en España tiene un riesgo de transmisión mínimo, según el Gobierno 08/11/2013El Ministerio de Sanidad ha informado de la detección en España del primer caso del nuevo coronavirus (MERS-CoV), importado por una mujer que viajó en octubre a Arabia Saudí. Este caso, identificado en Oriente Medio en 2012, "tiene un riesgo de transmisión en España mínimo", según el director del Centro de Coordinación de Alertas del Ministerio de Sanidad, Fernando Simón. Los coronavirus forman una amplia familia de virus que pueden ser responsables de dolencias leves, como los catarros, o de otras graves, como el Síndrome Agudo Respiratorio Severo (SARS). El caso detectado en España es uno de los 150 que se han comunicado a la Organización Mundial de la Salud desde septiembre de 2012, que incluyen 64 muertes. En un comunicado, el Ministerio informa de que la mujer, nacida en Marruecos pero residente en España, está ingresada en un hospital de Madrid y se encuentra "en situación favorable y estable". Más información SINC
Una exposición del pintor Antonio Calleja profundiza en la relación entre las matemáticas y la realidad 07/11/2013La galería madrileña AC Gallery Arte&Ciencia presenta hasta el 23 de noviembre una muestra pictórica del artista Antonio Calleja, con notable presencia de la física y las matemáticas como motivos de sus cuadros. Según la nota de prensa de la galería, se trata de una exposición "que profundiza en el misterio de la relación matemática/realidad o lo que es igual, de la relación mente/mundo". Cuadros inspirados en libros de divulgación científica (El quark y el jaguar, del Nobel de física Murray Gell-Mann), referencias al infinito y a los números irracionales, las galaxias... todos estos elementos aparecen en una muestra que está avalada por el científico Carlos Briones, investigador del Laboratorio de Evolución Molecular del Centro de Astrobiología del CSIC. Como explica Antonio Calleja en la revista Encuentros Multidisciplinares de la Universidad Autónoma de Madrid, "el Arte es la manifestación de la actividad humana mediante la cual se expresa una visión personal que interpreta lo real o imaginado con recursos plásticos, lingüísticos o sonoros. La Ciencia es el conjunto de conocimientos obtenidos mediante la observación y el razonamiento. Arte y Ciencia son inherentes al ser humano, son la expresión de nuestro conocimiento, son dos grandes formas del conocimiento humano.” Juan Pérez Mercader, miembro de la Academia Europea de Ciencias y Arte, e investigador en la Universidad de Harvard, explica su visión de la exposición: “Antonio Calleja muestra su interpretación de una buena serie de conceptos importantes en la Ciencia. Conceptos que generalmente están asociados a aspectos misteriosos de la misma. Lo hace con una técnica divulgativa en la que trata de acercar a la persona que mira su obra a los aspectos científicos del concepto mediante el estímulo potente de las imágenes con sus formas y colores que, de forma abstracta, transmiten su visión (la de Antonio Calleja) al espectador, al observador”. Más información Redacción T21
El bilingüismo tiene efectos positivos directos en la salud mental 07/11/2013Investigadores de varias instituciones de India y Reino Unido han descubierto que saber dos idiomas tiene efectos positivos directos en la salud mental. Los resultados del estudio, que ha incluido a 648 pacientes indios, han revelado que en promedio los individuos bilingües desarrollaban demencia cuatro años y medio más tarde que los monolingües. El trabajo, publicado esta semana en la revista Neurology, es el primero, además, en demostrar en personas analfabetas los beneficios en el cerebro de hablar dos lenguas, lo que, según los expertos, permite descartar la influencia del nivel educativo del individuo. El trabajo no encontró ningún efecto extra al incrementar el número de idiomas. Del conjunto de pacientes estudiados, con una edad media de 66 años, “la mitad era monolingüe y la otra mitad bilingüe”, indica a SINC Thomas H. Bak, uno de los autores e investigador de la Universidad de Edimburgo. Entre ellos, 240 tenían alzhéimer, 189 demencia vascular, 116 demencia frontotemporal y el resto diferentes formas mixtas de la enfermedad. “Todos fueron evaluados en un centro especializado para determinar la edad a la que presentaron los primeros síntomas”, señala Bak, “los pacientes bilingües habían desarrollado la dolencia entre cuatro y cinco años más tarde”. Los científicos han descartado que otros factores como el género, la edad, la profesión y la procedencia interfieran en el momento de aparición de las primeras manifestaciones. “Creemos que hablar más de un idioma produce un desarrollo más intenso de las áreas del cerebro encargadas de las funciones de ejecución y atención, lo que ayudaría a prevenir estas enfermedades”, explica Suvarna Alladi, otro de los autores y miembro del Instituto Nizam de Ciencias Médicas de Hyderabad (India). Bak destaca la importancia de llevar a cabo este tipo de estudios en España ya que “es el país multilingüe más importante de Europa y tiene centros importantes destinados a la investigación en este ámbito”, destaca. Más información SINC
El satélite GOCE culmina su investigación del campo gravitatorio terrestre 06/11/2013Después de más de cuatro años y medio de operación, el Explorador del campo Gravitatorio y de la Circulación regular Oceánica (GOCE), está próximo a finalizar su misión. Su vida útil ha sido de 35 meses. En los próximos días, probablemente el viernes, la nave se autodestruirá al entrar en la atmósfera y abandonar su última órbita operacional a una altitud de 229 km. Los científicos y técnicos estarán muy pendientes para seguir la evolución de los restos que se generen. GOCE, fabricado por Thales Alenia Space para la Agencia Espacial Europea (ESA), es el satélite más sofisticado jamás construido para investigar el campo gravitatorio de la Tierra. De hecho, ha facilitado el primer mapa de alta resolución del campo gravitatorio de la Tierra. Los datos obtenidos ya han sido ampliamente utilizados en aplicaciones de oceanografía, geofísica, geodesia, glaciología y climatología. Por su parte, el Vehículo Automatizado de Transferencia (ATV) Albert Einstein también ha completado con éxito su cuarta misión consecutiva de abastecimiento a la Estación Espacial Internacional. Durante los últimos cinco meses, en que ha permanecido atracado al complejo orbital, dio apoyo al control de actitud y órbita de la estación, y entregó toneladas de suministros. La nave logró un desatraque perfecto el 28 de octubre, seguido de una reentrada destructiva en la atmósfera –totalmente controlada– el 2 de noviembre. También estableció un nuevo récord de retirada de residuos de dos toneladas. Otro de los satélites que ha dejado recientemente de operar es el telescopio espacial Planck, también de la ESA, que fue desconectado el pasado 23 de octubre. Este satélite, puesto en órbita en 2009, estaba diseñado para analizar los débiles restos de la radiación del big bang, la denominada ‘radiación cósmica de fondo’. Según sus promotores, aunque la fase de observaciones científicas ya haya terminado, “el legado de esta misión sigue vivo”, y sus datos se seguirán analizando durante años. Más información SINC/ESA
La sonda Cassini obtiene una imagen simultánea de cinco satélites de Saturno 06/11/2013La sonda internacional Cassini presenta un bonito retrato de cinco lunas sobre los anillos de Saturno. Esta imagen de la cara norte e iluminada de los anillos de Saturno fue tomada el 29 de julio de 2011, cuando la sonda se encontraba justo por encima de su plano. En el extremo derecho, y tapando al propio Saturno, se encuentra su segunda mayor luna, Rea, de 1.528 km de diámetro. Es la más cercana a Cassini, a una distancia de 1.1 millones de kilómetros. Su superficie es testigo de una violenta historia, plagada de cráteres que solapan o incluso borran las huellas de impactos anteriores. Mimas, de 400 kilómetros de diámetro, se encuentra en segundo plano y justo por encima de los anillos interiores de Saturno. La silueta de su cráter más representativo, Herschel, está parcialmente cubierta por Rea y rodeada por una larga serie de cráteres más pequeños. El brillante Encélado se encuentra en el centro de la imagen y más allá de los anillos de Saturno, a una distancia de 1.8 millones de kilómetros de Cassini. Aunque no se puede apreciar en esta fotografía, su superficie está cubierta por una red de crestas y gargantas congeladas, y en su hemisferio sur presenta fisuras que lanzan chorros de partículas de hielo. Un poco más abajo y a la izquierda se puede distinguir a la pequeña Pandora, de apenas 81 kilómetros de diámetro. En esta imagen parece estar ensartada en los anillos exteriores de Saturno, ya que de hecho órbita entre los anillos A y F del planeta. Por último, en el extremo izquierdo se encuentra el irregular Jano, maquillado por las sombras de sus grandes cráteres de impacto. Más información ESA
Una nanopartícula mejora en un 83% la eficacia del fármaco contra la leishmaniasis 05/11/2013La Amphotericina B (AmB) es el principio activo del fármaco más efectivo que existe contra la leishmaniasis, una enfermedad que en el mundo occidental afecta principalmente a los perros, pero que en los países en vías de desarrollo afecta a más de 12 millones de personas, de las cuales más de 70.000 pierden la vida cada año. Las manifestaciones clínicas de la enfermedad van desde úlceras cutáneas que cicatrizan espontáneamente, hasta formas fatales en las cuales se presenta inflamación grave del hígado y del bazo El coste del tratamiento con AmB en las personas supera los 5.000 dólares por paciente, se trata de un tratamiento largo (sesiones de 2h diarias de inyecciones a lo largo de 21 días), los efectos secundarios son frecuentes y a menudo requieren la hospitalización del paciente. Investigadores de la Universidad de Miami (Floria) y de la Universidad Autónoma de Barcelona (UAB) han desarrollado un método que permite reducir drásticamente la dosis utilizada del fármaco, ya que mejora su eficacia en un 83%, multiplica por 10 la capacidad del fármaco de atacar las células afectadas por el parásito que provoca la enfermedad, y reduce significativamente la toxicidad del parásito. El complejo actúa por la acción de una nanopartícula, el PDD, una sustancia de unos 10 nanómetros de diámetro que se acopla al principio activo, la Amphotericina B, y lo guía selectivamente hacia las células que actúan como reservorio del parásito. La nanopartícula ya ha sido utilizada en ensayos con personas para incrementar la respuesta del sistema inmunitario en otras enfermedades. Ahora se necesitan estudios clínicos con humanos para comprobar su seguridad como adyuvante en el tratamiento de la leishmaniasis. Más información SINC/T21
Un sistema aprovecha el peso de los coches y peatones para producir electricidad 05/11/2013Emprendedores mexicanos han desarrollado un sistema que aprovechará el tráfico de vehículos para generar energía eléctrica. Ese desarrollo tiene la potencialidad de producir la electricidad necesaria para alimentar un hogar a través de un dispositivo que “atrapa” la fuerza de los automóviles en movimiento. “Se trata de una tecnología que provee energía sostenible y podría resultar bastante económica, pues es un complemento a la infraestructura ya existente: el hormigón de las calles y avenidas”, destaca Héctor Ricardo Macías Hernández, desarrollador del sistema, que agrega que a nivel mundial no existen antecedentes de proyectos similares, con excepción de una patente inglesa, pero con la diferencia de que en ese país europeo se emplean pisos piezoeléctricos, que resultan demasiado costosos para países en desarrollo. La tecnología consiste en un sistema que integra una rampa-escalón (elaborada a partir de material polimérico similar al de las llantas) que se eleva a cinco centímetros sobre el nivel del concreto. Al recibir el impacto provocado tanto por el tonelaje como por la inercia del vehículo, esa rampa ejerce presión sobre un fuelle. Este artefacto, al contener aire, lo expele a cierta presión a través de una manguera; posteriormente, ese elemento viaja hacia un tanque que lo comprime y lo relanza a una turbina generadora de electricidad. Macías Hernández comenta que la acumulación de energía eléctrica es proporcional al flujo de automóviles que existe sobre determinado lugar; sin embargo, explica que en un lugar con poca afluencia vehicular podrían ser colocadas varias rampas-escalón para multiplicar el impacto del paso del vehículo. La tecnología también podría ser implementada en lugares con alto flujo peatonal. De esa forma, los pasos de las personas estarían generando electricidad con base a las leyes de la energía gravitacional. Más información Investigación y Desarrollo/AlphaGalileo
Muere el profesor y académico José Luis Pinillos 05/11/2013Esta noche falleció el profesor y académico Jose Luis Pinillos. Tenía 94 años y deja tras de sí una estela de bonhomía y una obra, docencia y trabajo, que ha marcado el pensamiento en psicología social en la Universidad española José Luis Pinillos era Premio príncipe de Asturias de Ciencias Sociales de 1986, miembro de la Real Academia de Ciencias Morales y Políticas (RACMYP); de la Real Academia Española, RAE, y de la Academia del Foro Iberoamericano Sobre Estrategias de Comunicación, FISEC; Doctor honoris causa por las Universidades Pontificia de Salamanca, de Valencia, del País Vasco, de Santiago de Compostela, de Sevilla, de La Laguna, de Oviedo, Pontificia de Comillas y la UNED. En 1964 publicó su primera obra, "Introducción a la psicología contemporánea", a la que le siguieron: "Cuestiones de psicología evolutiva" (1964), "Constitución y personalidad. Historia y teoría de un problema" (1966) -en colaboración-, "La mente humana" (1969), "Grandeza y servidumbre de la metafísica" (1972), "Principios de psicología" (1975), "Más allá de Freud" (1976) "Psicopatología de la vida urbana" (1977) y "La psicología y el hombre de hoy" (1986), "Reconversión industrial y adaptación psicológica" (1986); "Psicología y psicohistoria" (1988), "Principios de psicología" (1995), "El corazón del laberinto" (1997) y "Principios de Psicología" (2002). Más información Redacción
El bótox podría aliviar el dolor de un tipo de cefaleas 04/11/2013Científicos de la Universidad Noruega de Ciencia y Tecnología (NTNU) están probando un nuevo tratamiento de bótox contra la cefalea en racimos. Erling Tronvik, en colaboración con el médico Daniel Bratbak del Hospital St. Olavs de Trondheim y el profesor Ståle Nordgård, también de la NTNU, utiliza una pistola con un cañón del grosor de una aguja, que se dispara alrededor de una zona nerviosa de la nariz. El proceso dura una media hora. "El efecto dura de tres a ocho meses. A continuación, el paciente tiene que recibir otra inyección", explica Tronvik. Pero aún deben comprobar su efectividad en un número mayor de personas, en torno a 40 personas con cefaleas de racimo y 80 con migrañas. Aunque en principio no debe ocurrir, los investigadores advierten a los voluntarios de que si el bótox se dispara demasiado cerca de la zona nerviosa, se puede provocar visión doble temporal o debilitar la capacidad del paciente para masticar. Más información AlphaGalileo/T21
Los perros "ven" las emociones de otros perros a través del movimiento de sus colas 04/11/2013Un grupo de investigadores del Centro Mente y Cerebro de la Universidad de Trento (Italia) describió, en un estudio publicado en 2007, que los perros mueven su cola a la derecha cuando sienten emociones positivas (al ver a sus dueños, por ejemplo) y a la izquierda cuando estos son sentimientos negativos (al ver un perro antipático). “Este primer trabajo dejó sin respuesta una pregunta básica: ¿Notan esa asimetría también otros perros?”, explica a SINC Giorgio Vallortigara. Para resolver esa duda, este mismo equipo de científicos hizo una nueva investigación, que publica la revista Current Biology. Los investigadores mostraron a distintos perros vídeos de otros canes que movían la cola hacia un lado o hacia el otro. Cuando los animales observaron que su semejante movía la cola a la izquierda, su ritmo cardíaco aumentó y comenzaron a sentirse ansiosos. Sin embargo, cuando vieron que el otro perro movía la cola hacia la derecha se quedaron perfectamente relajados. “No registramos la actividad en sus cerebros. Sólo lo observamos de forma indirecta”, señala el científico. La dirección en la que mueven la cola los perros importa, y coincide con la activación de los hemisferios del cerebro. El rabo a la izquierda coincide con una activación del hemisferio derecho, y viceversa. El investigador no cree que los perros lo hagan de forma intencionada para comunicar esas emociones a otros perros, sino más bien esos movimientos de la cola serían el resultado de una respuesta automática de la activación diferencial del hemisferio izquierdo y derecho del cerebro. Este tipo de respuestas podría tener aplicaciones prácticas para veterinarios y dueños de perros. "La estrategia de acercarse desde la izquierda o desde la derecha podría ser eficaz para los veterinarios durante las visitas de los animales o se podrían utilizar muñecos para explotar las asimetrías de sus respuestas emocionales", dice Vallortigara. “Las asimetrías en el comportamiento emocional están muy extendidas en el reino animal. Un ejemplo es el de los camaleones americanos machos que son más propensos a atacar cuando miran por el ojo izquierdo, o los sapos que detectan más fácilmente a una presa cuando ven con el ojo derecho”, concluye. Más información SINC
Reparando lesiones de la piel con cerámica 04/11/2013Las heridas profundas, las quemaduras y las ulceraciones en la piel pueden sanar en poco tiempo y sin dejar cicatrices gracias al uso del aluminofosfato, un tipo de cerámica que expertos del Instituto de Investigaciones en Materiales (IIM) de la Universidad Nacional Autónoma de México (UNAM) han probado con éxito en pacientes con pie diabético, cuyas lesiones precisaban amputación. En principio, la cerámica se usó en ratas Wistar, a las que previamente se les extirpó una porción de piel del lomo. “Los resultados fueron satisfactorios porque el tejido se reconstruyó, recuperó su grosor y textura normales y se pobló de pelo sin dejar marcas ni ocasionar infecciones”, afirma la doctora María Cristina Piña Barba, titular del proyecto. Después de comprobar los efectos de la biocerámica en roedores, el equipo científico tuvo la posibilidad de probarla en pacientes voluntarios con diabetes. “Estas personas presentaban ulceraciones y problemas de cicatrización, lesiones que se habían agravado al extremo de requerir amputación. No obstante, el uso del aluminofosfato permitió que las heridas cerraran y los salvó de perder el pie”, acota la investigadora. Y agrega que en el laboratorio han realizado distintas pruebas clínicas, proceso que les ha llevado más de 20 años de investigación. Asimismo, reconoce que el aluminofosfato ya había sido investigado en Cuba; no obstante, el máximo logro del equipo científico mexicano fue desarrollarlo en el laboratorio. Dicho material es del tipo de las zeolitas (mineral con porosidades cristalinas), está compuesto por una serie de canales en los que almacena agua y tiene la virtud de mantener al tejido seco y sin bacterias. De acuerdo con la doctora Piña Barba, a dichas cavidades del aluminofosfato se les introdujeron partículas de calcio y zinc, ya que juegan un papel importante en la cicatrización de la piel, reepitelización (formación de nuevas células cutáneas) y formación de tejido. El primer mineral regula y coordina la diferenciación de las nuevas células, participa en la formación de las capas grasas y proporciona protección. Y el otro elemento inactiva la acción perjudicial de las bacterias, reduce sangrados en heridas, promueve el desarrollo del tejido cutáneo y regenera el crecimiento de vello. La presentación del producto es en forma de polvo y puede aplicarse solo o mezclado con petrolato directamente en la lesión. Además, es económico, su elaboración es sencilla y puede usarlo cualquier persona con daños graves en la piel sin importar la causa. Investigación y Desarrollo
La ESA diseña una "caja mágica" para recoger muestras en Marte 31/10/2013Esta esfera de 23 centímetros de diámetro y menos de cinco kilos está diseñada para recoger rocas de Marte, y evitar que se contaminen, manteniéndolas a menos de -10°C durante el largo viaje de vuelta a la Tierra. Aunque todavía falten muchos años, traer muestras de Marte de vuelta a nuestro planeta es uno de los mayores retos de la exploración robótica del espacio. Un contenedor de muestras que sea robusto y multiuso es la pieza clave de una larga cadena de desafíos técnicos que hay que superar para que una misión de estas características cumpla con éxito sus objetivos. Según los supuestos en los que se basa el equipo de diseño, el contenedor tiene que aterrizar en Marte junto a un vehículo de exploración que recogerá una serie de muestras cuidadosamente seleccionadas por una misión anterior. Este contenedor en concreto cuenta con 11 receptáculos herméticos, entre los que se incluye uno diseñado específicamente para tomar muestras del aire marciano. Cuando se haya terminado de llenar, se pondrá de nuevo en órbita a Marte, donde permanecerá varios días esperando a su nave nodriza. Antes de regresar a la Tierra se tiene que encapsular en el interior de otro contenedor más grande, formando un sello biológico que evite la contaminación de las muestras. “Como existe la posibilidad, aunque sea muy remota, de que las muestras contengan formas de vida, tenemos que seguir los estrictos protocolos de protección planetaria, evitando cualquier contacto con la biosfera terrestre”, explica Benoit Laine, Responsable de la sección de Análisis y Verificación Térmica de la ESA, y supervisor de este proyecto. El conjunto regresará a nuestro planeta realizando una reentrada a gran velocidad. “La tecnología de los paracaídas todavía no está lo suficientemente madura, por lo que el contenedor tiene que ser capaz de soportar un aterrizaje sin paracaídas. El diseño de la misión no incluye ningún tipo de paracaídas; la cápsula caerá literalmente desde Marte hasta la Tierra, frenada sólo por la presión de la atmósfera sobre su escudo térmico y por el impacto contra el suelo”. Si bien este contenedor es más una prueba conceptual que un componente para una misión real, es completamente funcional y ya ha sido sometido a una serie de ensayos para simular el entorno térmico y el impacto a 400 g. Más información ESA
Reciclan el CO2 de la fabricación de cerveza sin usar agua y ahorrando mucha energía 31/10/2013Detrás de una caña de cerveza fría se oculta una revolución industrial que, sin estridencias, podría revolucionar la industria cervecera. Las cerveceras de todo el mundo recuperan desde hace casi dos décadas el CO2 generado durante la fermentación para utilizarlo en otras aplicaciones industriales, pero este proceso consume cantidades enormes de energía y agua. Union Engineering, una empresa de Dinamarca, ha desarrollado un método de fermentación ingenioso y mucho más respetuoso con el medio ambiente al que han denominado ECO2Brew. La iniciativa se basa en una tecnología avanzada de recuperación del CO2 y se puso en marcha en el proyecto financiado con fondos europeos Ficob. Gracias a ella es posible capturar el CO2 que se genera en las cisternas de fermentación para destinarlo al proceso de carbonatación de refrescos en otras líneas de producto e incluso otras fábricas. ECO2Brew está diseñado para funcionar sin agua y con un aporte considerablemente menor de energía y, aún así, es capaz de recuperar un mayor volumen de CO2 que otras tecnologías. Una planta de ECO2Brew capaz de producir mil kilogramos a la hora ahorra unos cuatro mil seiscientos metros cúbicos de agua al año y reduce el gasto energético en un veinte por ciento. El equipo de Union Engineering se embarcó en una asociación mixta con la cervecera danesa Carlsberg para llevar a la práctica en 2012 la nueva tecnología. En otoño de 2012 se inauguró la primera planta ECO2Brew en la planta cervecera de Carlsberg en Dinamarca. Carlsberg acaba de encargar una planta adicional de ECO2Brew en Finlandia. Más información Cordis
La minería del oro deforesta la Amazonía de Perú 30/10/2013En 2008, la crisis económica en Perú, asociada a un incremento del precio del oro, provocó un auge de la minería del preciado metal. Un estudio ha demostrado, mediante imágenes de satélite, mapas aéreos y datos de campo, que la superficie ocupada por esta actividad en la Amazonía occidental ha aumentado en un 400% entre 1999 y 2012, y que la tasa de deforestación que causa se ha triplicado. El trabajo, publicado esta semana en la revista PNAS y conducido por investigadores del Instituto Carnegie de Ciencias de Stanford (EE UU) y del Ministerio de Medio Ambiente peruano, analiza la evolución de las prospecciones mineras en torno a los ríos de la región de Madre de Dios (Perú), en plena selva amazónica. Según los autores, esta zona es especialmente rica en biodiversidad, y “una sola hectárea de la región tiene más de 300 especies de árboles”. Además, las reservas de carbono superan las 100 toneladas por hectárea y las poblaciones de depredadores como los jaguares y de grandes primates se incluyen entre las mayores del planeta. Los resultados revelan un aumento de la extensión ocupada por la minería de 10.000 hectáreas en 1999 a más de 50.000 en septiembre de 2012. Estas cifras superan todas las mediciones anteriores proporcionadas por el Gobierno peruano y otras organizaciones, que utilizaban técnicas tradicionales de cartografía por satélite. Los autores indican que este fuerte incremento se debe a la aparición de miles de nuevas explotaciones de actividad clandestina que en 2012 constituían el 51% de la minería total de la región. Más información SINC
|
|
||||||
|
|||||||

 Tendencias Científicas
Tendencias Científicas

CIENCIA ON LINE
CIENCIA ON LINE